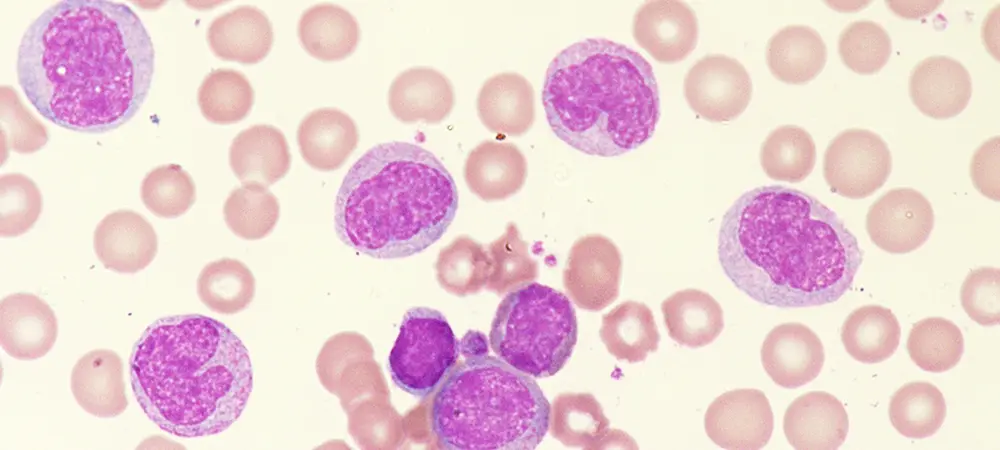

Lökositler diğer bir tanımla beyaz kan hücreleri, vücudu enfeksiyonlardan, iltihaplardan korumaya yardımcı olan hücrelerdir. Bağışıklık sisteminin önemli bir parçası olan beyaz kan hücreleri, kan dolaşımında yer alırlar. Lökositin normal değerleri yetişkinlerde 4.000-10.000 mikrolitredir. Kanın bir mikrolitresinde 11.000'den fazla beyaz kan hücresinin varlığı genellikle enfeksiyon ve iltihaplanmalara işaret edebilir. Düşüklüğü ise bağışıklığın zayıfladığına işaret edebilir.
Lökosit ne demektir?
Lökosit, kemik iliğinde üretilen ve kan ile lenf dokusunda yer alan bir kan hücresi çeşididir. Önemli görevleri arasında enfeksiyonlar ve çeşitli bazı hastalıklarla savaşmak yer alır. Lökositler vücuda giren yabancı maddelere karşı yanıt vererek beyaz kan hücresi üretirler. Kanda yer alan bu hücreler; iltihaplar, enfeksiyonlar virüsler ve diğer zararlı mikroorganizmalarla karşı vücudu korumaya fayda sağlarlar. Beyaz kan hücresi sayınız düşükse, enfeksiyon kapma riskiniz de artabilir. Eğer fazla ise bağışıklık sisteminden kaynaklanan farklı bir hastalığınız olabilir.
İdrarda lökosit ne anlama gelir?
Lökositler, bağışıklık sistemimizin önemli hücreleridir. Vücutta enfeksiyonlara ve hastalıklara karşı adeta kalkan görevi görürler. Hücreler yabancı maddeler karşısında saldırıya geçerek zararlı organizmaları devre dışı bırakırlar. İdrarınızdaki lökositler, bakteriyel bir enfeksiyona bağlı gelişebilir. Aynı zamanda idrarda lökosit, bulaşıcı bir enfeksiyonun yanı sıra idrar yolu enfeksiyonunun ya da farklı bir rahatsızlığın göstergesi olabilir. İdrar yolu enfeksiyonu, kadınlarda yaygın görülen bakterilerin idrar yollarına girmesi sonucu idrar sisteminde oluşan enfeksiyondur. İdrar yaparken ağrı ya da yanma hissi, sık idrara çıkma, aniden idrar yapma ihtiyacı gibi belirtilerle karakterize bir durumdur.
Kan tahlilinde lökosit ne anlama gelir?
Tam kan sayımı testi ile beyaz ve kırmızı kan hücresi sayınız incelenir. Kan tahlilinde yer alan lökosit değeri, vücudun enfeksiyonlara karşı savunmasında önemli olan beyaz kan hücrelerinin kandaki sayısını belirtir. Bağışıklık sisteminin sağlığı açısından önemli bir gösterge olan bu kan tahlili, WBC ile ölçülür. Beyaz kan hücreleri, yaralanma veya hastalıklara karşı çok ciddi savunma mekanizmasıdır. Lökositler, enfeksiyonun varlığında erkenden müdahale ederek patojenleri tanır ve yok eder. Bu sayede enfeksiyon yayılma riskinin önüne geçilir ve vücut, hastalıklara karşı güçlü bir savunma oluşturur.
Lökositin normal değeri kaç olmalı?
Lökositin kanda normal WBC sayısı mikrolitrede 4 bin-10 bin WBC’dir. Ancak bu değerler bazı laboratuvarlarda farklı olabilir. Sonuçlar hakkında doğru ve detaylı bilgiler almak adına doktorunuzla görüşmeniz daha iyidir. Normalden yüksek akyuvar sayısına lökositoz, düşük akyuvar sayısına ise lökopeni adı verilir. Farklı türde lökositler, bazı görevler üstlenir ve enfeksiyonların ortadan kaldırılması görevini bir arada yürütürler. Kan testleri ile değerlendirilen lökosit sayısı, vücudun genel sağlığına yönelik bazı bilgiler sunar. Aynı zamanda bu test hastalıkların erken teşhisinde önemli bir yer tutar.
Lökosit kaç olursa tehlikeli?
Genellikle, kanınızın bir mikrolitresinde 11 binden fazla beyaz kan hücresi mevcutsa, buna lökositoz adı verilir. Kanda çok fazla beyaz kan hücresi olması genellikle vücudunuzda enfeksiyon, iltihap veya stres kaynaklı bir durumun varlığına işaret edebilir. Şiddetli enfeksiyonlar bazı bağışıklık sistemi hastalıkları veya lösemi türlerini akla getirebilir. Kanda değeri yüksek olan lökositler, normal kan hücrelerini baskılayabilir. Lökosit yüksekliği bazen iltihaplanma sonucu eklemlerde, dokularda ve organlarda ağrılara sebep olabilir. Ayrıca bağışıklığın verdiği bir tepki sonucu ateş ve halsizlik gibi enfeksiyonlara bağlı belirtiler de ortaya çıkabilir.
Lökosit yüksekliği neyi gösterir?
Lökosit yüksekliği, vücudunuzda normalden daha fazla lökosit olduğunu gösterir. Genellikle vücudun enfeksiyonla savaştığını gösterir.
Lökosit yüksekliği şu durum ve hastalıklara işaret edebilir;
Enfeksiyon
Vücudunuz bir enfeksiyonla savaştığında, lökositler de artabilir. Virüs, bakteri, mantar ve parazit enfeksiyonları beyaz kan hücrelerinin artışına sebep olabilir.
İltihaplı hastalıklar
Romatizmal hastalıklar, organ kanserleri, iltihabi bağırsak hastalıkları veya lupus gibi bağışıklık sistemi sorunlarında değerler yükselebilir.
Yaralanmalar
Vücudunuz bir yaralanmaya yanıt verdiğinde, lökositler yaralanma bölgesine akar ve iyileşme sürecine yardımcı olur. Lökasitlerin artmasının bir nedeni de bu durumdur.
Kan hastalıkları
Çeşitli kan hastalıkları durumunda lökosit seviyeleri ciddi oranda artabilir. Lösemi ve lenfoma gibi kanserler kanda lökositin ciddi oranda artışına sebep olur.
Lökosit düşüklüğü nedir?
Düşük beyaz kan hücresi sayısı, normalden daha az beyaz kan hücresine sahip olduğunuzda ortaya çıkar. Kandaki beyaz kan hücresi sayısının normalin altında olduğu bu durum çeşitli hastalıklara ve bazı ilaçların kullanımına bağlı gelişebilen bir durumdur. Lökosit düşüklüğü viral enfeksiyonlar, otoimmün hastalıklar ya da beslenme yetersizliğine bağlı ortaya çıkabilir.
Lökosit düşüklüğüne neden olabilecek durum ve hastalıklar şöyle sıralanabilir;
- Şiddetli enfeksiyonlar
- Kemik iliği yetmezliği
- Beslenme bozuklukları
- Grip ve nezle gibi virüslerden kaynaklanan hastalıklar
- Vitamin eksiklikleri
- Romatizmal hastalıklar
- Radyoterapi ve kemoterapi gibi durumlar
- Karaciğer rahatsızlıkları
- Otoimmün bozukluklar
Lökosit değerleri nasıl artırılır?
Beyaz kan hücrelerinin bağışıklık sisteminizde oynadığı kritik rolü anlamak, uygun bir sayıyı korumanın önemini vurgular niteliktedir. Yaşam tarzı ve beslenme alışkanlıklarında bazı değişiklikler yapmak lökosit değerlerinin arttırmanın önemli bir yoludur. Aynı zamanda yeterli ve dengeli beslenme sağlık açısından da çok önemlidir. Bu durumda çeşitli besin açısından zengin yiyecekleri beslenmenize dâhil etmek faydalıdır. Özellikle A vitamini, C vitamini ve antioksidanlar açısından zengin besinler, bağışıklık sisteminizi güçlendirmenin yanı sıra akyuvar üretimini artırmaya destek olabilir. Ayrıca hareketli bir yaşam tarzına sahip olmak, stresi yönetebilmek ve uyku düzenine dikkat etmek lökosit üretimine yardımcı olabilir. Alkol, beyaz kan hücrelerinin üretiminden sorumlu olan kemik iliği fonksiyonuna zarar verebilir. Alkol ve sigara alımınızı azaltmak ya da bu alışkanlıkları bırakmak beyaz kan hücresi sayınızın tekrar yükselmesini sağlayabilir.